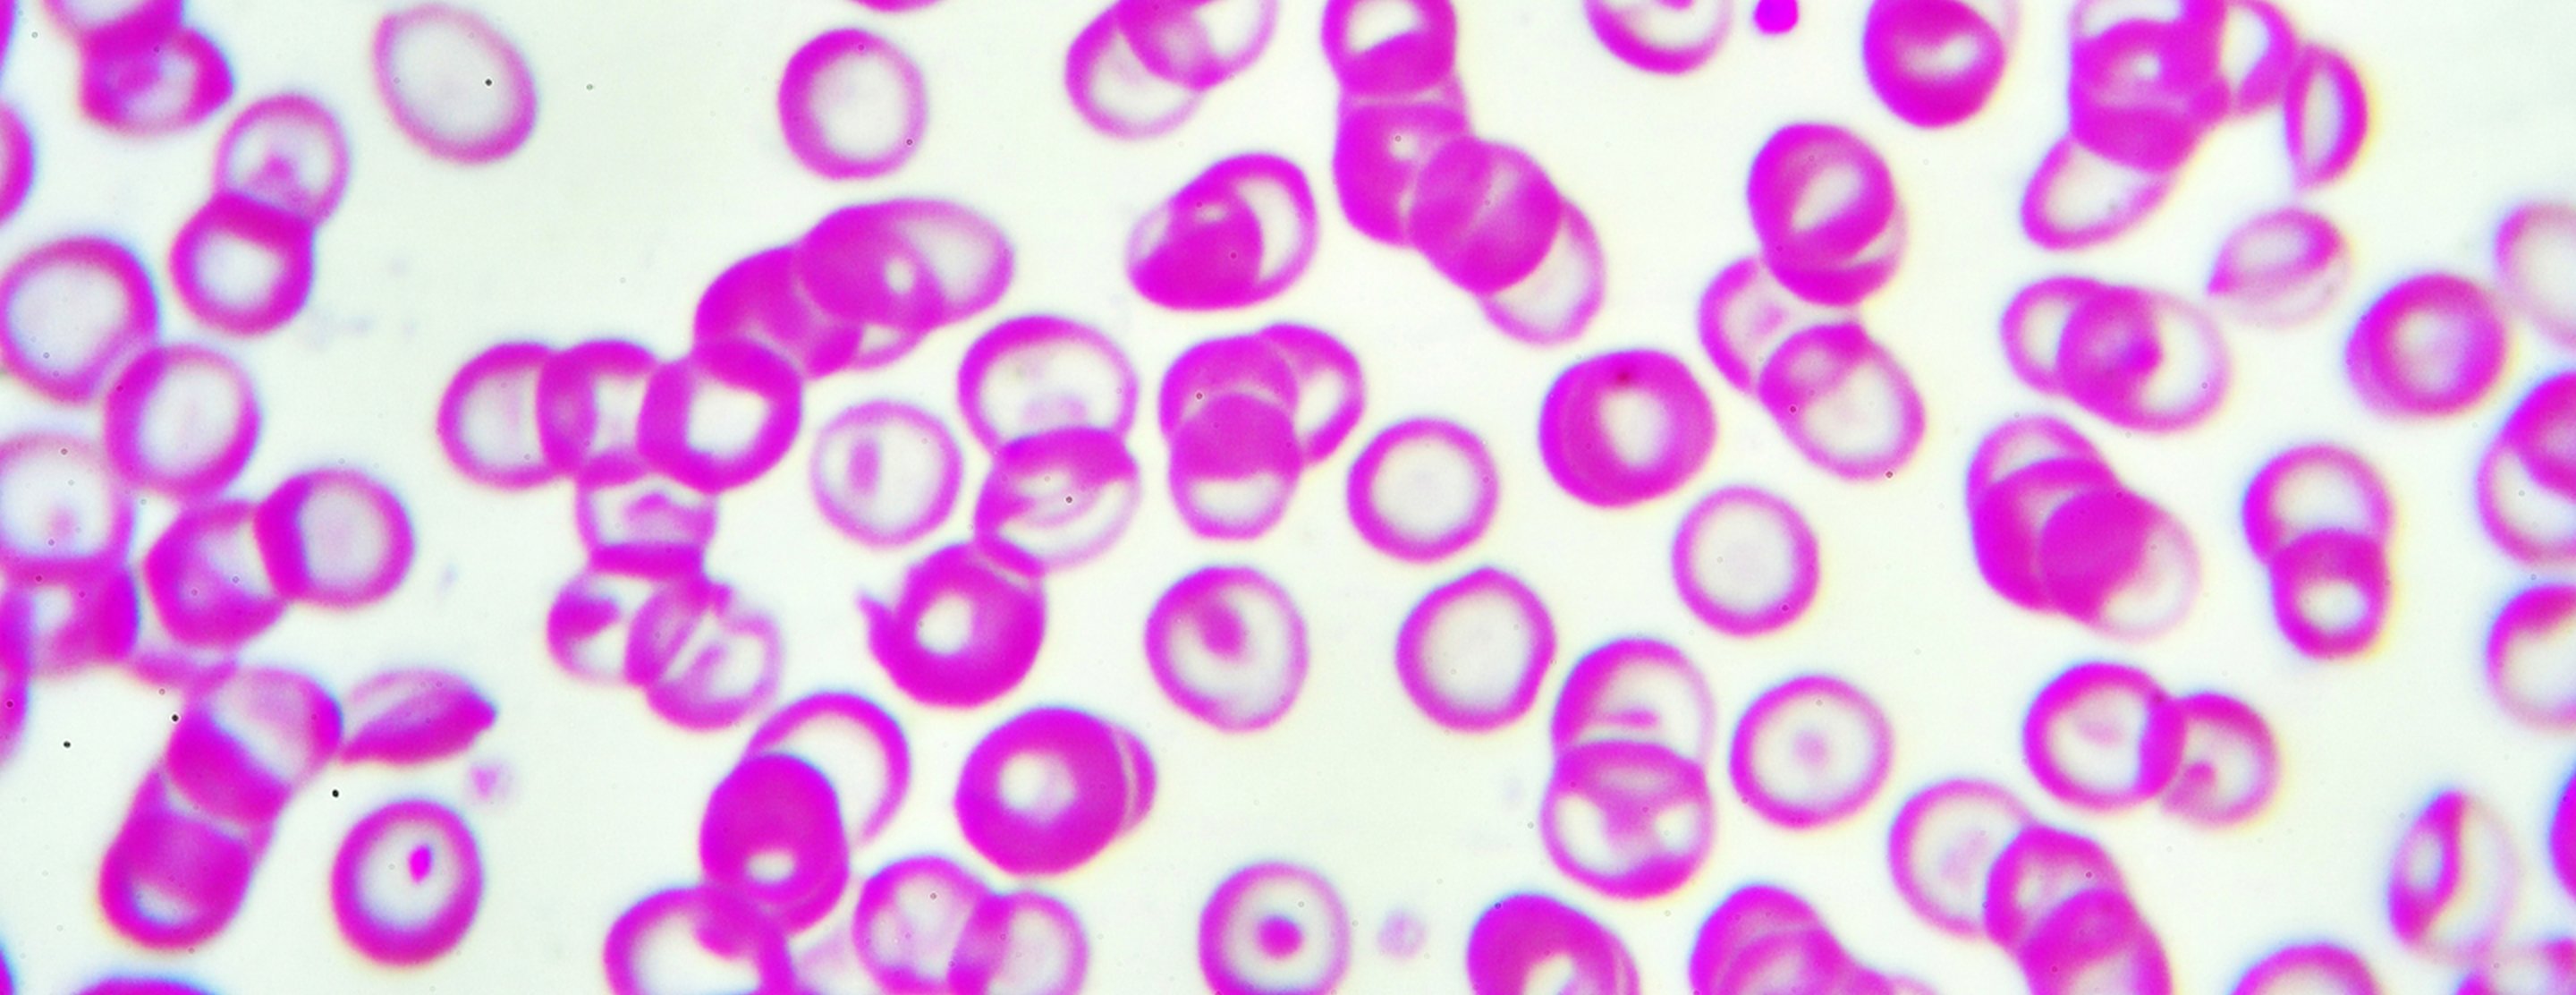

Hypochromia
Definition
Hypochromia means that the red blood cells have less color than normal when examined under a microscope. This usually occurs when there is not enough of the pigment that carries oxygen (
The most common cause of hypochromia in the United States is not enough iron in the body (iron deficiency). If it is not treated, this can lead to a disorder called
The cause of hypochromia should be evaluated by your health care provider.
References
Camaschella C. Disorders of iron homeostasis: iron deficiency and overload. In: Hoffman R, Benz EJ, Silberstein LE, et al, eds. Hematology: Basic Principles and Practice. 8th ed. Philadelphia, PA: Elsevier; 2023:chap 37.
DeLoughery TG. Microcytic and hypochromic anemias. In: Goldman L, Cooney KA, eds. Goldman-Cecil Medicine. 27th ed. Philadelphia, PA: Elsevier; 2024:chap 145.
Vajpayee N, Graham SS, Bem S. Basic examination of blood and bone marrow. In: McPherson RA, Pincus MR, eds. Henry's Clinical Diagnosis and Management by Laboratory Methods. 24th ed. Philadelphia, PA: Elsevier; 2022:chap 31.
Review Date: 03/31/2024
The information provided herein should not be used during any medical emergency or for the diagnosis or treatment of any medical condition. A licensed physician should be consulted for diagnosis and treatment of any and all medical conditions. Call 911 for all medical emergencies. Links to other sites are provided for information only -- they do not constitute endorsements of those other sites. Copyright ©2019 A.D.A.M., Inc., as modified by University of California San Francisco. Any duplication or distribution of the information contained herein is strictly prohibited.
Information developed by A.D.A.M., Inc. regarding tests and test results may not directly correspond with information provided by UCSF Health. Please discuss with your doctor any questions or concerns you may have.